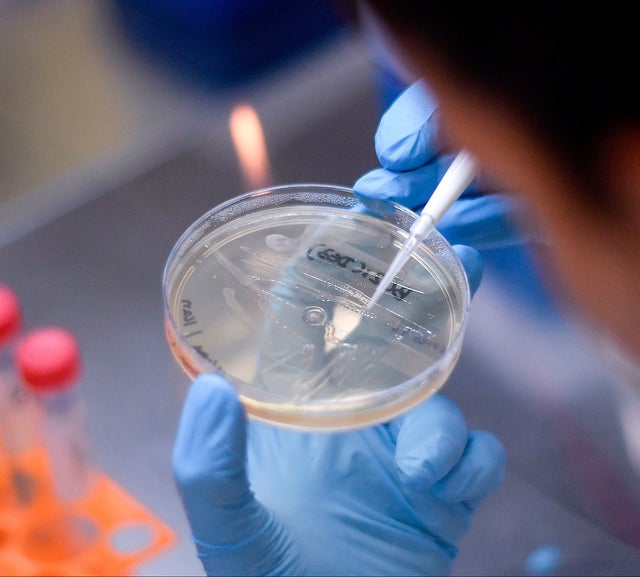

What Coronavirus Vaccines

5 Things Everyone Should Know About The Coronavirus Outbreak Stories At Yale Medicine
www.yalemedicine.org

Coronavirus Vaccine India Will Have Approved Covid Vaccine By 2021 Q1 Report India News Times Of India
timesofindia.indiatimes.com


Why Are Australian Church Leaders Opposing The Oxford Coronavirus Vaccine Vaccines And Immunisation The Guardian
www.theguardian.com

Just 50 Of Americans Plan To Get A Covid 19 Vaccine Here S How To Win Over The Rest Science Aaas
www.sciencemag.org

Novel Coronavirus Structure Reveals Targets For Vaccines And Treatments National Institutes Of Health Nih
www.nih.gov